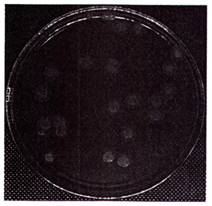
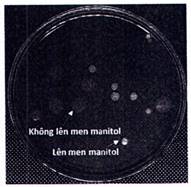
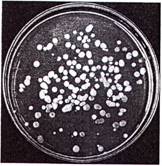
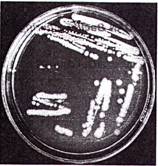
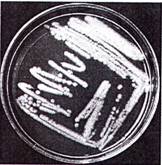

- Tổng quan
- Nội dung
- Tiêu chuẩn liên quan
- Lược đồ
- Tải về
Tiêu chuẩn quốc gia TCVN 14114:2024 Phân bón - Định lượng Bacillus thuringiensis bằng kỹ thuật đếm khuẩn lạc
| Số hiệu: | TCVN 14114:2024 | Loại văn bản: | Tiêu chuẩn Việt Nam |
| Cơ quan ban hành: | Bộ Khoa học và Công nghệ | Lĩnh vực: | Công nghiệp , Nông nghiệp-Lâm nghiệp |
| Trích yếu: | Phân bón - Định lượng Bacillus thuringiensis bằng kỹ thuật đếm khuẩn lạc | ||
|
Ngày ban hành:
Ngày ban hành là ngày, tháng, năm văn bản được thông qua hoặc ký ban hành.
|
14/08/2024 |
Hiệu lực:
|
Đã biết
|
| Người ký: | Đang cập nhật |
Tình trạng hiệu lực:
Cho biết trạng thái hiệu lực của văn bản đang tra cứu: Chưa áp dụng, Còn hiệu lực, Hết hiệu lực, Hết hiệu lực 1 phần; Đã sửa đổi, Đính chính hay Không còn phù hợp,...
|
Đã biết
|
TÓM TẮT TIÊU CHUẨN VIỆT NAM TCVN 14114:2024
Nội dung tóm tắt đang được cập nhật, Quý khách vui lòng quay lại sau!
Tải tiêu chuẩn Việt Nam TCVN 14114:2024
TIÊU CHUẨN QUỐC GIA
TCVN 14114:2024
PHÂN BÓN - ĐỊNH LƯỢNG BACILLUS THURINGIENSIS BẰNG KỸ THUẬT ĐẾM KHUẨN LẠC
Fertilizers - Enumeration of Bacillus thuringiensis by colony count method
Lời nói đầu
TCVN 1411:2024 do Học viện Nông nghiệp Việt Nam biên soạn, Bộ Nông nghiệp và Phát triển Nông thôn đề nghị, Tổng cục Tiêu chuẩn Đo lường Chất lượng thẩm định, Bộ Khoa học và Công nghệ công bố.
PHÂN BÓN - ĐỊNH LƯỢNG BACILLUS THURINGIENSIS BẰNG KỸ THUẬT ĐẾM KHUẨN LẠC
Fertilizers - Enumeration of Bacillus thuringiensis by colony count method
1 Phạm vi áp dụng
Tiêu chuẩn này quy định phương pháp định lượng Bacillus thuringiensis trong phân bón hay nguyên liệu sản xuất phân bón bằng kỹ thuật đếm khuẩn lạc trên môi trường thạch.
2 Tài liệu viện dẫn
Các tài liệu viện dẫn sau là rất cần thiết cho việc áp dụng tiêu chuẩn này. Đối với tài liệu viện dẫn ghi năm công bố thì áp dụng bản được nêu. Đối với tài liệu viện dẫn không ghi năm công bố thì áp dụng phiên bản mới nhất, bao gồm cả các bản sửa đổi, bổ sung (nếu có).
TCVN 6404:2016 (ISO 7218:2007 with amendment 1:2013) Vi sinh vật trong thực phẩm và thức ăn chăn nuôi - Yêu cầu chung và hướng dẫn kiểm tra vi sinh vật.
TCVN 8128:2015 (ISO 11133:2014) Vi sinh vật trong thực phẩm, thức ăn chăn nuôi và nước-chuẩn bị, sản xuất, bảo quản và thử hiệu năng của môi trường nuôi cấy.
TCVN 6507-1: 2005 (ISO 6687-1) Vi sinh vật trong thực phẩm và thức ăn chăn nuôi - Chuẩn bị mẫu thử, huyền phù ban đầu và các dung dịch pha loãng thập phân để kiểm tra vi sinh vật - Phần 1: Các nguyên tắc chung để chuẩn bị huyền phù ban đầu và các dung dịch pha loãng thập phân.
3 Thuật ngữ và định nghĩa
Trong tiêu chuẩn này sử dụng các thuật ngữ, định nghĩa sau đây:
3.1
Vi khuẩn Bacillus thuringiensis
Là vi khuẩn gram dương, tạo bào tử, mang các gen cry mã hóa các protein tinh thể độc; có khả năng tiêu diệt sâu hại, ấu trùng của một số loài côn trùng gây hại cho cây trồng.
3.2
Vi khuẩn Bacillus thuringiensis giả định
Vi sinh vật hình thành khuẩn lạc đặc trưng trên bề mặt môi trường thạch MYP và T3; có các đặc điểm hình thái, tạo tinh thể được mô tả khi tiến hành các thử nghiệm theo tiêu chuẩn này.
CHÚ THÍCH 1: Có thể sử dụng môi trường nuôi cấy vi khuẩn sinh màu là các sản phẩm đang bán sẵn trên thị trường. Thông tin này đưa ra nhằm tạo thuận lợi cho người dùng tiêu chuẩn.
3.3
Định lượng Bacillus thuringiensis
Xác định số lượng tế bào vi khuẩn Bacillus thuringiensis (3.2) (CFU/g hoặc CFU/mL) trong một khối lượng hoặc thể tích cụ thể của phân bón vi sinh chứa vi sinh vật khi tiến hành các thử nghiệm theo tiêu chuẩn này.
4 Nguyên tắc
Định lượng Bacillus thuringiensis trong phân bón, nguyên liệu sản xuất phân bón bằng kỹ thuật đếm số lượng đơn vị khuẩn lạc đặc trưng phát triển trên môi trường thạch và được khẳng định thông qua đặc điểm hình thái, sinh hóa và sự có mặt của protein tinh thể độc.
5 Môi trường, hóa chất
5.1 Yêu cầu chung
Sử dụng các loại hóa chất tinh khiết chuyên dùng cho phân tích vi sinh vật và theo khuyến cáo của nhà sản xuất. Chuẩn bị, sản xuất và thử hiệu năng môi trường nuôi cấy theo TCVN 8128:2015 (ISO 11133:2014).
5.2 Nước, nước cất hoặc nước có chất lượng tương đương để pha chế hoá chất, môi trường nuôi cấy vi sinh vật [xem TCVN 6404:2016 (ISO 7218:2007 with amendment 1:2013)].
5.3 Môi trường Luria-Bertani (LB)
5.3.1 Thành phần
Tryptone (peptone từ casein) 10,0 g
Cao nấm men (yeasr extract) 5,0 g
Sodium chloride (NaCl) 5,0 g
Thạch (Agar) 20,0 g
Nước cất Lên thể tích đến 1000 mL
pH 7,0 ±0,2 ở 25 °C
Không bổ sung agar khi chuẩn bị môi trường LB lỏng; ưu tiên sử dụng các môi trường thương mại (nếu có).
5.3.2 Chuẩn bị
Cân và hòa tan các thành phần trong nước theo thứ tự đã liệt kê tại mục (5.3.1) hoặc môi trường hoàn chỉnh khô theo hướng dẫn của nhà sản xuất; Phân phối môi trường với lượng phù hợp vào các bình thủy tinh (6.2.2); Không vặn chặt nắp bình và khử trùng ở điều kiện 121 °C, 15 min sử dụng nồi hấp tiệt trùng (6.1.1); Điều chỉnh pH sao cho sau khi khử trùng, môi trường có pH 7,0 ± 0,2 ở 25 °C; Làm nguội môi trường đến 44 °C - 47 °C, phân phối lượng khoảng 18 mL đến 20 mL môi trường vào các đĩa Petri (6.2.3) đã được chuẩn bị nêu tạo mục 6.2; Khi môi trường đã đông đặc, làm khô bề mặt thạch trước khi sử dụng bằng cách lật úp các đĩa thạch và ủ trong tủ ấm (6.1.3) ở nhiệt độ 25 °C - 37 °C trong 20 -25 min. Nếu chưa dùng ngay, bảo quản các dĩa thạch ở (4 ± 1) °C trong ngăn mát tủ lạnh (6.1.5), sử dụng trong vòng một tuần.
5.4 Môi trường T3
Môi trường dinh dưỡng có tác dụng kích thích tạo bào tử, làm ổn định cấu trúc protein tinh thể của vi khuẩn Bacillus thuringiensis và ức chế hoàn toàn hoặc một phần các nhóm vi sinh vật khác. Trên môi trường T3, Bacillus thuringiehsis có các đặc điểm đặc trưng về hình thái khuẩn lạc, bào tử và tinh thể được mô tả khi tiến hành các thử nghiệm theo tiêu chuẩn này.
5.4.1 Thành phần
Tryptone (peptone từ casein) 3,0 g
Cao nấm men (yeast extract) 1,5 g
Tryptose 2,0 g
Mangan(ll) clorua (MnCI2) 0,005 g
Natri Dihydro Photphat (NaH2PO4) 6,9 g
Natri hidrophotphat (Na2HPO4) 8,9 g
Thạch (Agar) 20,0 g
Nước Lên thể tích đến 1000 mL
pH 7,0 ±0,2 ở 25 °C
5.4.2 Chuẩn bị
Cân và hòa tan các thành phần trong nước theo thứ tự đã liệt kê tại mục (5.4.1) hoặc môi trường hoàn chỉnh khô theo hướng dẫn của nhà sản xuất; Phân phối môi trường với lượng phù hợp vào các bình thủy tinh (6.2.2); Không vặn chặt nắp binh và khử trùng ở điều kiện 121 °C, 15 min sử dụng nồi hấp tiệt trùng (6.1.1); Điều chỉnh pH sao cho sau khi khử trùng, môi trường có pH 7,0 ± 0,2 ở 25 °C; Làm nguội môi trường đến 44 °C - 47 °C, phân phối lượng khoảng 18 mL đến 20 mL môi trường vào các dĩa Petri (6.2.3) đã được chuẩn bị nêu tạo mục 6.2; Khi môi trường đã đông đặc, làm khô bề mặt thạch trước khi sử dụng bằng cách lật úp các đĩa thạch và ủ trong tủ ẩm (6.1.3) ở nhiệt độ 25 °C - 37 °C trong 20 -25 min. Nếu chưa dùng ngay, bảo quản các đĩa thạch ở (4 ± 1) °C trong ngăn mát tủ lạnh (6.1.5), sử dụng trong vòng một tuần.
5.5 Môi trường Mannitol egg Yolk Polymyxin agar (thạch MYP)
Môi trường giúp phân lập nhóm vi khuẩn Bacillus cereus (bao gồm Bacillus anthracis, Bacillus cereus, Bacillus mycoides, Bacillus pseudomycoides, Bacillus thuringiensis và Bacillus weihenstephanensis) với các vi khuẩn khác dựa trên cơ sở hoạt động của lecithinase, lên men mannitol và khả năng kháng polymyxin. Môi trường này ức chế hoàn toàn hoặc một phần sự sinh trưởng của các nhóm vi sinh vật khác. Trên môi trường thạch MYP, Bacillus thuringiensis có đặc điểm hình thái và phản ứng sinh hóa đặc trưng được mô tả ở mục (7.4).
5.5.1 Môi trường cơ bản
5.5.1.1 Thành phàn
Cao thịt bò (beef extract) 1,0 g
Tryptone (pepton từ casein) 10,0 g
D-mannitol (C6H14O6) 10,0 g
Sodium chloride (NaCl) 10,0 g
Phenol đỏ (C19H14O5S) 0,025 g
Thạch (Agar) 20,0 g
Nước Lên thể tích đến 1000 mL
pH 7,0 ±0,2 ở 25 °C
5.5.1.2 Chuẩn bị
Cân và hòa tan các thành phần trong nước theo thứ tự đã liệt kê tại mục (5.5.1.1) hoặc môi trường hoàn chỉnh khô theo hướng dẫn của nhà sản xuất; Phân phối môi trường với lượng phù hợp vào các bình thủy tinh (6.2.2); Không vặn chặt nắp bình và khử trùng ở điều kiện 121 °C, 15 min sử dụng nồi hấp tiệt trùng (6.1.1). Điều chỉnh pH sao cho sau khi khử trùng, môi trường có pH 7,0 ± 0,2 ở 25 °C.
CHÚ THÍCH 2: Ưu tiên sử dụng các sản phẩm thương mại trong thành phần có sẵn Polymyxin (5.5.2) và thực hiện theo hướng dẫn của nhà sản xuất.
5.5.2 Dung dịch polymyxin B
5.5.2.1 Thành phần
Polymyxin B sulfate 106 IU (IU là đơn vị đo quốc tế)
Nước 100 mL
5.5.2.2 Chuẩn bị
Chuẩn bị dung dịch polymyxin B: hòa tan Polymyxin B sunfate trong nước và lọc để khử trùng bằng màng lọc có kích thước lỗ 0,22 μm (6.2.5).
5.5.3 Dung dịch nhũ tương lòng đỏ trứng
Chọn các quả trứng gà còn nguyên vẹn và rửa sạch vỏ bằng xà phòng; Tráng sạch dưới vòi nước chảy và ngâm trong cồn 95% trong 30 sec, để khô; Trong trong tủ cấy vô trùng (6.1.2), đập vỡ quả trứng và tách riêng lòng đỏ trứng gà bằng cách chuyển lòng đỏ từ nửa vỏ này sang nửa vỏ còn lại; Cho lòng đỏ vào ống ly tâm 50 mL có vạch chia (6.2.8), bổ sung nước (5.2) đã hấp khử trùng theo thể tích với tỷ lệ 1:4 và khuấy bằng cách lắc đều; Ủ hỗn hợp trong bể ổn nhiệt (6.1.11) ở nhiệt độ 44 °C - 47 °C trong 2 h, sau đó để hỗn hợp trong ngăn mát tủ lạnh (6.1.5) ở (4 ± 1) °C trong 18-24 h để tạo kết tủa; Kết thúc thời gian ủ, thu nhũ tương phía trên, bảo quản ở nhiệt độ ở (4 ± 1) °C và sử dụng trong vòng 72 h.
5.5.4 Môi trường MYP hoàn chỉnh
5.5.4.1 Thành phần
Môi trường cơ bản (5.5.1) 90,0 mL
Dung dịch polymyxin B (5.5.2) 1,0 mL
Dung dịch nhũ tương lòng đỏ trứng (5.5.3) 10,0 mL
5.5.4.2 Chuẩn bị
Môi trường MYP cơ bản sau khi hấp tiệt trùng như đã nêu tại mục (5.5.1.2) được làm nguội ở nhiệt độ phòng đến nhiệt độ khoảng 44 °C - 47 °C; Trong thời gian làm nguội môi trường, ủ dung dịch nhũ tương lòng đỏ trứng (5.5.3) trong bể ổn nhiệt (6.1.11) ở nhiệt độ 44 °C - 47 °C; Sau đó, cho lần lượt các dung dịch dung dịch polymyxin B (5.5.2) và dung dịch nhũ tương lòng đỏ trứng (5.5.3) vào môi trường thạch MYP cơ bản (5.5.1), trộn đều hỗn hợp và phân phối lượng khoảng 18 mL đến 20 mL môi trường vào các đĩa Petri (6.2.3) đã được chuẩn bị như nêu tạo mục 6.2; Khi môi trường đã đông đặc, làm khô bề mặt thạch trước khi sử dụng bằng cách lật úp các đĩa thạch và ủ trong tủ ấm (6.1.3) ở nhiệt độ 25 °C - 37 °C trong 20 -25 min. Nếu chưa dùng ngay, bảo quản các đĩa thạch ở (4 ± 1) °C trong ngăn mát tủ lạnh (6.1.5), sử dụng trong vòng một tuần. Các thao tác được tiến hành trong tủ cấy vô trùng (6.1.2).
5.6 Thuốc nhuộm Gram
Bộ thuốc nhuộm Gram thương phẩm (dung dịch tím tinh thể, dung dịch lugol, dung dịch tẩy màu ethanol 90%, dung dịch safranin) và dung dịch Fuchsin 0,3%.
5.6.1 Thành phần dung dịch Fuchsin
| Fuchsin basis (C20H20N3CI) | 3,0 g |
| Ethanol 95% (C2H6O) | 10,0 mL |
| Phenol tinh thể (C6H6O) | 5,0 g |
| Nước cất | 90 mL |
5.6.2 Chuẩn bị
Cân và hòa tan Fuchsin trong ethanol 95% thu được dung dịch (A); Hòa tan phenol tinh thể trong nước cất đã được làm nóng đến 70 °C ở bể ổn nhiệt (6.1.11) thu được dung dịch (B); Trộn dung dịch (A) và (B) thu được dung dịch Fuchsin và bảo quản ở nhiệt độ phòng.
5.7 Thuốc nhuộm tinh thể
5.7.1 Thành phàn
Coomassie brilliant blue G-250 (C47H48N3NaO7S2) 0,25 g
Ethanol 100% (C2H6O) 50 mL
Acid acetic (CH3COOH) 7 mL
Nước cất Lên thể tích đến 100 mL
5.7.2 Chuẩn bị
Cân và hòa tan các thành phần đã liệt kê tại mục 5.7.1 trong bình thủy tinh (6.2.2). Lên thể tích bằng nước cất đến 100 mL và bảo quản lạnh ở (4 ± 1) °C.
5.8 Dung dịch pha loãng
5.8.1 Thành phần
Sodium chloride (NaCl) 8,5 g
Nước 1000 mL
pH 7,0 ± 0,2 ở 25 °C
5.8.2 Chuẩn bị
Cân và hòa tan các thành phần đã liệt kê tại mục 5.8.1 trong 1000 mL nước và để trong bình thủy tinh (6.2.2); Phân phối dung dịch pha loãng với lượng 90,0 mL vào các bình thủy tinh (6.2.2) và 9,0 mL mỗi ống nghiệm (6.2.11). Không vặn nắp và khử trùng ở điều kiện 121 °C, 15 min sử dụng nồi hấp tiệt trùng (6.1.1). Sai số cho phép đo của thể tích cuối cùng sau khi khử trùng không được vượt quá ± 0,2 %.
5.9 Hoá chất tách chiết ADN
Hóa chất sử dụng để đề tách chiết axit nucleic không được liệt kê ở đây mà phụ thuộc vào phương pháp đã được chấp nhận, tham khảo phụ lục B.
5.10 Mồi phát hiện và thành phần phản ứng PCR
Các mồi dùng để phát hiện các trình tự gen đích đặc hiệu bằng PCR tiêu chuẩn được liệt kê trong Phụ lục C
Thành phần phản ứng PCR: Sử dụng các bộ kít thương mại phù hợp với điều kiện thực tế của phòng thử nghiệm và thực hiện theo hướng dẫn của nhà sản xuất.
6 Thiết bị, dụng cụ
Sử dụng các thiết bị, dụng cụ của phòng thử nghiệm vi sinh thông thường [xem TCVN 6404:2016 (ISO 7218:2007 with amendment 1:2013)]
6.1 Thiết bị
6.1.1 Nồi hấp tiệt trùng áp lực, có khả năng duy trì nhiệt độ (121 ± 3) °C, tương đương áp suất tối thiểu 101,3 kPa.
6.1.2 Tủ cấy vi sinh vật, đảm bảo độ vô trùng.
6.1.3 Tủ ấm, thông gió đối lưu, có khả năng duy trì nhiệt độ từ 25 °C đến 37 °C, độ chính xác đến 1 °C.
6.1.4 Tủ sấy, thông gió đối lưu, có khả năng sấy ở nhiệt độ lên tới 70 °C (nếu mục đích sấy vô trùng thì nhiệt độ là 160 °C), độ chính xác đến 1 °C.
6.1.5 Tủ lạnh, với ngăn đông có thể duy trì nhiệt độ ổn định ở -20 °C ± 1 °C và ngăn lạnh duy trì nhiệt độ ổn định ở (4 ± 1) °C
6.1.6 Máy trộn mẫu (máy vortex), có khả năng khuấy trộn mẫu đồng đều.
6.1.7 Máy đo pH, có bù nhiệt, chính xác đến ±0,1 đơn vị ở 25 °C.
6.1.8 Cân kỹ thuật (cân chính xác đến 0,01 g).
6.1.9 Kính hiển vi quang học, vật kính có độ phóng đại 4X, 10X, 40X và vật kính dầu 100X.
6.1.10 Lò vi sóng.
6.1.11 Bể ổn nhiệt (water bath), có khả năng điều chỉnh nhiệt độ lên đến (99 ± 1) °C.
6.1.12 Máy li tâm, có khả năng điều chỉnh tốc độ quay tối đa 14000 rpm và nhiệt độ đến (4 ± 1) °C.
6.1.13 Máy PCR, có khả năng khuếch đại được ADN của mẫu.
6.1.14 Máy đo nồng độ ADN
6.1.15 Máy chụp ảnh gel điện di
6.2 Dụng cụ
Các dụng cụ sử dụng trong nuôi cấy vi sinh vật phải tiệt trùng ở điều kiện 121 °C, 15 min sử dụng nồi hấp tiệt trùng (6.1.1) và sấy khô bằng tủ sấy (6.1.4) trước khi tiến hành bất kỳ thử nghiệm nào.
6.2.1 Pipet, có thể phân phối 0,05 mL ± 0,002 mL, 0,1 mL ± 0,02 mL, 1,0 mL + 0,02 mL và 10 mL ± 0,2 mL.
6.2.2 Bình cấy hoặc bình thủy tinh, có dung tích thích hợp, có nút đậy kín hoặc nắp vặn thích hợp.
6.2.3 Đĩa Petri, bằng chất dẻo hoặc thủy tinh không màu trong suốt, đường kính 90 mm, chiều sâu tối thiểu là 10 mm.
6.2.4 Đầu hút vô trùng các loại, có khả năng chịu nhiệt.
6.2.5 Màng lọc, vô trùng, màng xenluloza axetat, cỡ lỗ 0,22 μm.
6.2.6 Que dàn mẫu, bằng thủy tinh hoặc kim loại có thể tiệt trùng.
6.2.7 Que cấy, đầu tròn bằng nhựa hoặc kim loại.
6.2.8 Ống ly tâm, 15 mL và 50 mL, làm bằng nhựa chịu nhiệt, có vạch chia đến 5 ml.
6.2.9 Lam kính
6.2.10 Đèn cồn
6.2.11 Ống nghiệm, làm bằng nhựa chịu nhiệt, có nắp đậy.
6.2.12 Ống ly tâm 1,5 mL và 2,0 mL làm bằng nhựa chịu nhiệt, có vạch chia đến 0,5; 1, 1,5 và 2,0 mL.
6.2.13 Ống PCR ,có thành mỏng, chịu nhiệt (0,2 mL).
7 Cách tiến hành
7.1 Lấy mẫu
Lấy mẫu theo TCVN 12105:2018
7.2 Chuẩn bị mẫu thử và các dung dịch pha loãng
Thực hiện theo TCVN 6507-1: 2005 (ISO 6687-1) và các tiêu chuẩn riêng liên quan. Cụ thể như sau:
Dùng cân kỹ thuật (6.1.8) cân 10 g mẫu hoặc dùng pipet (6.2.1) với đầu hút vô trùng (6.2.4) hút 10 mL mẫu cho vào bình thủy tinh (6.2.2) chứa 90 mL dung dịch pha loãng đã chuẩn bị như nêu tại 5.8.2. Trộn đều mẫu trên máy vortex (6.1.6) cho đến khi đồng nhất mẫu và ủ mẫu trong bể ổn nhiệt (6.1.11) ở 80 °C trong 5 min nhằm diệt các tế bào sinh dưỡng và các tế bào không sinh bào tử. Dung dịch phía trên sau khi phần tử nặng lắng xuống được gọi là dung dịch huyền phù ban đầu có độ pha loãng 10-1.
Dùng pipet (6.2.1) với đầu hút vô trùng (6.2.4) hút 1 mL dịch huyền phù ban đầu cho vào ống nghiệm (6.2.11) chứa 9 mL dung dịch pha loãng đã chuẩn bị như nêu tại 5.8.2. Tránh chạm đầu tip vào dung dịch pha loãng. Trộn kỹ trên máy trộn vortex (6.1.6) khoảng 10 sec, dung dịch thu được có nồng độ 10-2. Lặp lại quy trình để thu được dung dịch có các nồng độ pha loãng thập phân tiếp theo. Thường sử dụng nồng độ pha loãng 10-5, 10-6, 10-7 đối với phân bón vi sinh và nồng độ pha loãng 10-3, 10-4, 10-5 đối với các phân bón khác có chứa vi sinh vật.
CHÚ THÍCH 3: Hoạt hóa mẫu (nếu có) theo hướng dẫn của nhà sản xuất để đảm bảo kết quả chính xác.
7.3 Cấy và ủ mẫu
Sử dụng pipet (6.2.1) với đầu hút vô trùng (6.2.4) hút 0,1 mL dung dịch mẫu ở các nồng độ pha loãng cho vào mỗi đĩa Petri (6.2.3) chứa môi trường thạch MYP (5.5.4) đã chuẩn bị. Mỗi nồng độ thực hiện 2 đĩa.
Dùng que dàn mẫu (6.2.6) dàn đều dịch cấy trên bề mặt đĩa thạch càng nhanh càng tốt. Sử dụng một que dàn mẫu vô trùng cho mỗi đĩa. Đậy nắp đĩa và để ở nhiệt độ phòng trong khoảng 15 min để dịch cấy hấp thụ vào bề mặt thạch.
Lập úp các đĩa đã chuẩn bị và nuôi trong tủ ấm (6.1.3) ở 37 °C trong 24 h - 48 h. Nếu sau thời gian trên, các khuẩn lạc chưa hình thành hoặc hình thành nhưng không rõ ràng, ủ đĩa thêm 24h nữa.
7.4 Đếm và nhận diện khuẩn lạc
Đếm các khuẩn lạc Bacillus thuringiensis giả định ở hai độ pha loãng liên tiếp, trên các đĩa Petri có chứa từ 10 đến 300 khuẩn lạc.
Trên môi trường thạch MYP, khuẩn lạc Bacillus thuringiensis giả định là các khuẩn lạc có màu hồng (cho thấy không lên men mannitol, xem chú thích 4) và thường được bao quanh bởi một vùng kết tủa (cho thấy hình thành lecithinase, xem chú thích 5) (xem Hình 1 và Hình A.1, Phụ lục A).
CHÚ THÍCH 4: Nếu các dĩa chứa nhiều vi sinh vật lên men mannitol dẫn đến sinh axit thì màu hồng đặc trưng của khuẩn lạc Bacillus thuringiensis có thể bị nhạt đi hoặc biến mất hoàn toàn.
CHÚ THÍCH 5: Một số chủng Bacillus thuringiensis chỉ sinh ít hoặc không sinh lecithinase. Các khuẩn lạc thuộc các chủng này sẽ không có vùng kết tủa bao quanh.
Khuẩn lạc của một số vi sinh vật thuộc nhóm vi khuẩn Bacillus cereus có thể xuất hiện màu sắc, hình dạng tương tự như Bacillus thuringiensis giả định. Các khuẩn lạc này có thể được nhận diện và loại trừ bằng phép thử khẳng định.
Hình 1. Khuẩn lạc Bacillus thuringiensis trên môi trường thạch MYP sau 24 h
7.5 Khẳng định
7.5.1 Lựa chọn môi trường và khuẩn lạc
Từ mỗi đĩa Petri đã chọn (7.4), lấy ít nhất năm khuẩn lạc Bacillus thuringiensis giả định để thực hiện phép thử khẳng định.
Dùng que cấy đầu tròn (6.2.7) lấy sinh khối các khuẩn lạc Bacillus thuringiensis giả định trên môi trường MYP (7.4) cấy trên thạch đĩa Petri chứa môi trường T3 (5.4), ủ đĩa ở 37 °C trong thời gian nhất định được nêu rõ khi thực hiện các thử nghiệm trong phép thử khẳng định. Trên môi trường T3, khuẩn lạc Bacillus thuringiensis giả định có đặc điểm đặc trưng như khuẩn lạc màu trắng sữa, hình tròn, bề mặt trơn nhẵn và hình thành tinh thể độc (Hình A.2, Phụ lục A).
7.5.2 Đánh giá đặc điểm hình thái, bào tử
Chuẩn bị tiêu bản: Sử dụng lam kính (6.2.9) đã được ngâm trong ethanol 90% và lau khô bằng giấy mềm. Nhỏ một giọt nước vô trùng lên lam kính, dùng que cấy đầu tròn (6.2.7) lấy một ít sinh khối vi khuẩn đã được cấy trên môi trường T3 ở 37 °C trong 24h dàn đều trên lam kính, cố định tiêu bản bằng cách hơ nhẹ trên ngọn lửa đèn cồn (6.2.10) cho đến khi không quan sát thấy giọt nước trên lam kính.
Nhuộm màu: Nhỏ dung dịch tím tinh thể (5.6) lên vi khuẩn, để trong 1 min rồi rửa lại bằng nước cất. Sau đó nhỏ dung dịch lugol (5.6) để cố định màu trong 1 min và rửa lại bằng nước cất. Tiếp theo, khử màu bằng ethanol 90% (5.6) trong 30 sec rồi rửa bằng nước cất. Cuối cùng, nhuộm bằng dung dịch fucshin 0.3 % trong 1 min, rửa bằng nước cất và để khô hoàn toàn ở nhiệt độ phòng. Soi tiêu bản dưới kính hiển vi quang học vật kính 100X (6.1.9).
7.5.3 Nhuộm tinh thể
Đặc trưng quan trọng nhất để khẳng định Bacillus thuringiensis đó là sự hình thành tinh thể độc.
Chuẩn bị tiêu bản: Sử dụng lam kính (6.2.9) đã được ngâm qua cồn và lau khô bằng giấy mềm. Nhỏ một giọt nước vô trùng lên lam kính, dùng que cấy đầu tròn (6.2.7) lấy một ít sinh khối vi khuẩn đã được cấy trên môi trường T3 ở 37 °C trong ít nhất 72 h dàn đều trên lam kính, cố định tiêu bản bằng cách hơ trên ngọn lửa đèn cồn (6.2.10) cho đến khi không quan sát thấy giọt nước trên lam kính.
Nhuộm màu: Nhỏ dung dịch nhuộm tinh thể (5.7) lên vi khuẩn, để yên trong 3 min, rửa bằng nước cất và để khô hoàn toàn ở nhiệt độ phòng. Soi tiêu bản dưới kính hiển vi quang học vật kính 100X (6.1.9).
CHÚ THÍCH 6:
1) Chỉ có thể quan sát thấy tinh thể khi các bào tử đã được giải phóng. Nếu sau thời gian nuôi vi khuẩn giả định trên môi trường T3 ở 37 °C sau 72 h vẫn không quan sát thấy tinh thể, tiến hành nuôi thêm từ 24 - 48 h nữa và quan sát lại sự có mặt của tinh thể. Trong trường hợp không quan sát thấy tinh thể, các khuẩn lạc giả định này được thực hiện thêm phép thử khẳng định bằng việc phát hiện gen đích đặc hiệu thông qua phản ứng PCR tiêu chuẩn (Phụ lục C).
2) Các chủng Bacillus thuringiensis có thể hình thành các dạng tinh thể với hình dạng khác nhau. Phổ biến nhất là tinh thể dạng hình thoi.
7.5.4 Đọc kết quả
Các khuẩn lạc giả định thu được kết quả như sau được xác định là Bacillus thuringiensis.
Bảng 1: Các kết quả của phép thử khẳng định
| STT | Phép thử | Kết quả khẳng định | Phụ lục | |
| 1 | Môi trường thạch MYP (7.4) | Lên men manitol | Âm tính | Hình A.1 |
| Phản ứng lecithinase | Dương tính | |||
| 2 | Đánh giá đặc điểm hình thái tế bào, bào tử (môi trường T3) (7.5.2) | Hình thái khuẩn lạc | Khuẩn lạc màu trắng sữa, hình tròn hoặc dẹt, bề mặt trơn nhẵn. | Hình A.2 |
| Nhuộm gram | Dương tính | Hình A.3 (A) | ||
| Hình dạng tế bào | Tế bào hình que, đầu hơi tù, xếp thành chuỗi, bắt màu tím. | |||
| Hình thành bào tử | Dương tính | |||
| Hình dạng bào tử | Bào tử có dạng oval dài | |||
| 3 | Nhuộm tinh thể (7.5.3) | Hình thành tinh thể | Dương tính | Hình A.3 (B) |
| Dạng tinh thể | Tinh thể độc màu xanh da trời có dạng hình thoi, hình tam giác, hình quả trám. | |||
Các khuẩn lạc được khẳng định là Bacillus thuringiensis sẽ được nuôi cấy và giữ giống trên môi trường LB đã chuẩn bị (5.1) và trong glycerol 30%.
8. Biểu thị kết quả
8.1 Tính số lượng Bacillus thuringiensis trong mẫu thử
- Số lượng khuẩn lạc Bacillus thuringiensis trên mỗi đĩa Petri theo các tiêu chí xác định được tính theo công thức (1)
|
| (1) |
Trong đó:
b là số lượng khuẩn lạc Bacillus thuringiensis giả định cho thấy có đặc điểm như phép thử khẳng định của tiêu chuẩn;
A số lượng khuẩn lạc Bacillus thuringiensis giả định đã qua phép thử khẳng định;
C tổng số khuẩn lạc Bacillus thuringiensis giả định đếm được trên đĩa Petri.
Làm tròn kết quả tính được đến số nguyên gần nhất.
- Tổng số N vi khuẩn Bacillus thuringiensis đã được nhận dạng/khẳng định có trong mẫu thử được tính theo công thức (2):
|
| (2) |
Trong đó:
a số lượng Bacillus thuringiensis trong một đơn vị kiểm tra, được tính bằng đơn vị hình thành khuẩn lạc trên gam hay mililit (CFU/g (mL));
∑a tổng số khuẩn lạc Bacillus thuringiensis đếm được trên tất cả các đĩa Petri được giữ lại ở hai độ pha loãng liên tiếp;
0,1 thể tích mẫu cấy trên mỗi đĩa Petri, tính bằng mililit (mL);
n1 số đĩa Petri được giữ lại ở độ pha loãng thứ nhất;
n2 số đĩa Petri được giữ lại ở độ pha loãng thứ hai;
d độ pha loãng tương ứng với dung dịch pha loãng thứ nhất được giữ lại.
Làm tròn kết quả tính được đến một chữ số sau dấu phẩy. Biểu thị kết quả bằng cách lấy một trong các giá trị từ 1,0 đến 9,9 nhân với 10x, trong đó x là số mũ của 10.
8.2 Báo cáo kết quả trong trường hợp đặc biệt
Biểu thị kết quả trong trường hợp số đếm thấp hoặc trường hợp đặc biệt theo quy định trong TCVN 6404:2016 (ISO 7218:2007 with amendment 1:2013). Cụ thể như sau:
8.2.1 Nếu 2 đĩa không chứa khuẩn lạc
Nếu hai đĩa chứa mẫu thử (sản phẩm dạng lỏng) hoặc huyền phù ban đầu (sản phẩm dạng khác) hoặc dung dịch pha loãng thứ nhất được nuôi cấy không chứa khuẩn lạc nào thì báo cáo kết quả như sau:
- Nếu thể tích dịch nuôi cấy là 0,1 mL: số khuẩn lạc < 10 CFU/mL (sản phẩm dạng lỏng không pha loãng) hoặc <10/d CFU/g (sản phẩm dạng khác).
- Nếu thể tích dịch nuôi cấy là 1 mL: số khuẩn lạc < 1 CFU/mL (sản phẩm dạng lỏng không pha loãng) hoặc <1/d CFU/g (sản phẩm dạng khác).
8.2.2 Nếu 2 dĩa mỗi đĩa ít hơn 10 khuẩn lạc
Nếu hai đĩa chứa mẫu thử (sản phẩm dạng lỏng) hoặc huyền phù ban đầu (sản phẩm dạng khác) hoặc dung dịch pha loãng thứ nhất được nuôi cấy chứa ít hơn 10 khuẩn lạc thì báo cáo kết quả như sau:
| Đối với sản phẩm lỏng không pha loãng | Đối với sản phẩm dạng khác |
|
|
|
| N: số lượng Bacillus thuringiensis trong trong 1 ml (CFU/ml); | N: số lượng Bacillus thuringiensis trong trong 1 g (CFU/g); |
| ∑C: tổng các khuẩn lạc đếm được trên 2 đĩa. | |
| V (mL): thể tích dịch nuôi cấy trên mỗi đĩa. | |
| d: hệ số pha loãng | |
9 Báo cáo thử nghiệm
Báo cáo thử nghiệm phải được viết phù hợp với các tiêu chuẩn TCVN hiện hành, bao gồm ít nhất các thông tin sau:
• các thông tin cần thiết để nhận biết đầy đủ về mẫu thử;
• phương pháp lấy mẫu đã sử dụng (nếu biết);
• phương pháp thử nghiệm đã dùng hoặc viện dẫn tiêu chuẩn này;
• các thao tác không quy định trong tiêu chuẩn này, hoặc các lưu ý, sự cố có thể ảnh hưởng đến kết quả;
• kết quả thử nghiệm thu được.
PHỤ LỤC A – KẾT QUẢ KHẢO SÁT ĐẶC ĐIỂM HÌNH THÁI, SINH HOÁ VÀ TINH THỂ CỦA VI KHUẨN Bacillus Thuringiensis
(Qui định)
|
Đối chứng âm |
Vi khuẩn Bacillus thuringiensis NBRC 101235 |
Vi khuẩn Bacillus thuringiensis giả định |
Đánh giá khả năng lên men manitol
Hình A.1. Kết quả đánh giá khả năng lên men manitol và sinh lecithinase của vi khuẩn Bacillus thuringiensis
Sinh enzyme lecithinase:
+ Phản ứng dương tính: xung quanh khuẩn lạc có vòng tủa
+ Phản ứng âm tính: xung quanh khuẩn lạc không có vòng tủa
Lên men manitol:
+ Phản ứng dương tính: biến đổi màu môi trường từ hồng sang vàng, khuẩn lạc màu trắng đục hoặc vàng nhạt
+ Phản ứng âm tính: không đổi màu môi trường, khuẩn lạc màu hồng
|
Khuẩn lạc Bacillus thuringiensis |
Khuẩn lạc Bacillus thuringiensis NBRC 101235 |
Khuẩn lạc Bacillus thuringiensis giả định |
Hình A.2. Hình thái khuẩn lạc vi khuẩn Bacillus thuringiensis trên môi trường T3 sau 24h
Khuẩn lạc Bacillus thuringiensis màu trắng sữa, hình tròn hoặc dẹt, bề mặt trơn nhẵn

Hình A.3. Tế bào (A), bào tử và tinh thể (B) của vi khuẩn Bacillus thuringiensis
Vi khuẩn gram dương, bắt màu tím, tế bào chuỗi hình que; Bào tử có dạng oval dài; tinh thể bắt màu xanh hình thoi hoặc quả trám.
PHỤ LỤC B - PHƯƠNG PHÁP TÁCH CHIẾT ADN
(Tham khảo)
Sử dụng quy trình tách chiết ADN thích hợp đối với vi khuẩn Gram dương hoặc có thể tham khảo quy trình tách chiết ADN dưới đây. Ngoài ra, có thể sử dụng các bộ kit thương mại theo hướng dẫn của nhà sản xuất.
B.1. Hóa chất tách chiết
B.1.1 Thành phần đệm tách chiết ADN (đệm CTAB)
Cetyltrimethylammonium bromide (CTAB) 0,5 g
Ethylenediaminetetraacetic acid (EDTA) 1,0 g
Tris (hydroxymethyl) aminomethane (Tris base) 2,5 g
Sodium chloride (NaCl) 5,0 g
Nước cất 100 mL
B.1.2 Chuẩn bị
Cân và hòa tan các thành phần đã liệt kê trong bình thủy tinh. Lên thể tích 100 mL bằng nước cất. Không đậy nắp và khử trùng ở điều kiện 121 °C, 15 min sử dụng nồi hấp tiệt trùng (6.1.1) và bảo quản ở nhiệt độ phòng.
B.1.3 Các hoá chất khác
- Lysozyme
- Chloroform, Isopropanol
- SDS 20%
- Ethanol 100% và 70%
- Đệm TE (10 mM Tris-HCl; 1 mM EDTA)
- β-Mercaptoethanol
- Agarose
- Loading dye
Có thể sử dụng các bộ kít tách chiết ADN thương mại phù hợp với điều kiện thực tế của phòng thử nghiệm và thực hiện theo hướng dẫn của nhà sản xuất. Thông tin này đưa ra nhằm tạo thuận lợi cho người dùng tiêu chuẩn.
B.2. Tách chiết ADN vi khuẩn
Các chủng vi khuẩn Bacillus thuringiensis được tách chiết ADN theo quy trình trong TLTK [5] và có một số điều chỉnh. Các khuẩn lạc được nuôi cấy tăng sinh trong 2 mL môi trường LB lỏng lỏng ở 37 °C trong 20 h. Cụ thể như sau:
Bước 1: Hút 2 mL dịch nuôi vi khuẩn vào ống eppendorf 2 mL (6.2.4), ly tâm 10000 g trong 1 min. Loại bỏ dịch nồi.
Bước 2: Hòa tan cặn khuẩn trong 70 pL dung dịch đệm TE (1:10), vortex đều. Sau đó, bổ sung thêm 15 μl Lysozyme (20 mg/mL), trộn đều và ủ ở 37 °C trong 30 min.
Bước 3: Bổ sung 700 μl đệm chiết CTAB và 1,2 μl P-Mercaptoethanol. Vortex đều.
Bước 4: Bổ sung 60 μl SDS 20%. Bổ sung 3 viên bi sắt (6.2.12) vào mỗi ống, vortex trong 3 min.
Bước 5 : Ủ mẫu ở 65 °C trong 30 min. Trong quá trình ủ cứ 10 min đảo trộn đều.
Bước 6: Loại bỏ bi sắt, chuyển dịch sang ống 2 mL mới.
Bước 7: Bổ sung 800 μl hỗn :hợp PhenolChloroform:lsoamylalcohol (25:24:1), trộn đều tạo huyền phù sau đó ly tâm 13700 g ở 4 °C trong 8 min.
Bước 8: Hút 500 μl dịch nổi phía trên chuyển sang ống mới sau đó bổ sung hỗn hợp Chloroform: Isoamylalcohol (24:1) theo tỷ lệ 1:1 (tính theo thể tích dịch thu được ở bước 7). Trộn đều bằng vortex.
Bước 9: Ly tâm ở 13700 g ở 4 °C trong 10 min.
Bước 10: Chuyển dịch nổi (400 μL) vào ống eppendorf 1,5 mL (6.2.4).
Bước 11: Bổ sung ethanol tuyệt đối (ethanol lạnh) với tỷ lệ 2 ethanol: 1 dịch thu được (v/v) ở bước 10. Nhẹ nhàng đảo trộn đều 6-8 lần.
Bước 12: Ly tâm ở 10000 g, 4 °C trong 7 min.
Bước 13: Đồ dịch nổi, rửa kết tủa ADN với 500 pL dung dịch ethanol 70%.
Bước 14: Ly tâm ở 5400 g, 4 °C trong 5 min, sau đó loại bỏ dịch nổi để khô trong không khí.
Bước 15: Hoà tan kết tủa trong 50 μL nước cất hoặc TE.
Bước 16: Bảo quản ADN sau khi tách chiết ở -20 °C.
B.3. Xác định hàm lượng và độ sạch của ADN
ADN sau tách chiết được xác định hàm lượng và độ tinh sạch sử dụng phương pháp đo quang phổ bằng máy đo nồng độ ADN (6.1.14) và điện di trên gel agarose 1,0%. Nồng độ ADN thu được nên tối thiểu là 20 ng trong 1 μl dịch ADN, giá trị A260/280 ≥ 1,8, A260/230 tốt nhất trong khoảng 2,0 - 2,2.
Có thể sử dụng các kỹ thuật tách chiết ADN khác nhau để thu được ADN với chất lượng đảm bảo được quy định trong tiêu chuẩn này.
PHỤ LỤC C - PHÁT HIỆN Bacillus thuringiensis BẰNG PHƯƠNG PHÁP PCR SỬ DỤNG CÁC GEN ĐÍCH ĐẶC HIỆU VÀ PHÁT HIỆN CÁC SẢN PHẨM CỦA PHẢN ỨNG PCR BẰNG ĐIỆN DI TRÊN GEL AGAROSE
(Quy định)
Các khuẩn lạc nghi ngờ (Chú thích 6) mô tả trong tiêu chuẩn này được thử phép thử khẳng định bằng việc sử dụng gen cặp mồi phát hiện gen XRE hoặc Cry2.
- Gen điều hòa phiên mã XRE (transcriptional regulator XRE gene): vùng CDS (coding sequence) gen XRE chứa motif helix -turn -helix (HTH) đặc trưng của họ protein XRE (XRE-like protein family) và họ gen điều hòa phiên mã MerR (MerR family transcriptional regulators). HTH protein tham gia vào một loạt các con đường tín hiệu ví dụ như ức chế sự hình thành bào tử, sự tiết các enzyme phân giải protein; gen có kích thước ~ 246 bp.
- Gen mã hoá tinh thể Cry2 (crystal protein gene): một trong các gen mã hóa cho tinh thể độc của Bacillus thuringiensis; gen có kích thước ~ 700 bp.
Tính đặc hiệu của cặp mồi đối với các chủng Bacillus thuringiensis thử nghiệm được xác nhận theo TLTK [6] và quy định trong tiêu chuẩn này.
C.1 Mồi PCR
Các mồi dùng để phát hiện các trình tự gen đích đặc hiệu bằng PCR tiêu chuẩn được liệt kê trong bảng sau, tham khảo TLTK [6]:
Bảng C1 - Mồi đặc hiệu phát hiện Bacillus thuringiensis
| Gen | Môi | Trình tự oligonucleotit | Nồng độ gốc | Nhiệt độ gắn mồi | Kích thước (bp) |
| XRE | 657_3TF | 5’-AAGATATTGCAAGCGGTAAGAT-3’ | 10 μM | 54,9 °C | 246 |
| 657_3TR | 5’-GTTTTGTTTCAGCATTCCAGTAA-3’ | 10 μM | |||
| Cry2 | Cry2-F | 5’-GTTATTCTTAATGCAGATGAATGGG-3’ | 10 μM | 56,7 °C | 700 |
| Cry2-R | 5'-CGGATAAAATAATCTGGGAAATAGT-3’ | 10 μM |
C.2 Thực hiện phản ứng PCR
C.2.1 Chuẩn bị phản ứng PCR
Bảng C2- Thành phần hỗn hợp phản ứng PCR cho trình tự đích XRE và Cry2
| Thành phần | Nồng độ gốc | Thể tích (μl) |
| Nuclease- Free Water | - | 6,0 |
| PCR Master Solution | 2X | 10,0 |
| Mồi xuôi | 10 μM | 1,0 |
| Mồi ngược | 10 μM | 1,0 |
| ADN | 10 ng/μl | 2,0 |
| Tổng thể tích | 20 | |
Trộn đều hỗn hợp phản ứng bằng pipet hoặc vortex sau đó li tâm nhanh.
Lưu ý: Quy trình luôn phải thực hiện song song mẫu thử nghiệm các mẫu sau đây:
+ Mẫu đối chứng trắng (ADN khuôn được thay bằng nước);
+ Mẫu đối chứng âm (negative control) là mẫu ADN không phải của Bacillus thuringiensis
+ Mẫu đối chứng dương (positive control) là ADN của chủng chuẩn Bacillus thuringiensis
C.2.2 Chu trình nhiệt PCR
Bảng C3 - Chương trình nhiệt độ và thời gian
| Chu trình nhiệt | |||
| Bước | Nhiệt độ | Thời gian | Chu kỳ |
| 1 | 95 °C | 5 min | 1 |
| 2 | 95 °C | 30 see | 35 |
| Nhiệt độ gắn mồi theo bảng 1 | 30 sec | ||
| 72 °C | 1 min | ||
| 3 | 72 °C | 7 min | 1 |
| 4 | 20 °C | ~ | ~ |
C.2.3 Điện di sản phẩm PCR
10 μl sản phẩm PCR được bổ sung 2 μl loading dye được kiểm tra bằng cách điện di trên gel agarose 1% trong đệm 1 xTAE, dòng điện có hiệu điện thế 80 V trong 45 min và chụp ảnh bằng máy chụp gel (6.1.15).
C.2.4 Kết quả phản ứng PCR
Khẳng định vi khuẩn Bacillus thuringiensis dựa trên kết quả điện di được công nhận như sau: khuẩn lạc nghi ngờ cho sản phẩm đặc hiệu đúng kích thước (gen XRE ~ 246 bp và gen Cry2 ~ 700 bp).

Hình C.1. Kết quả điện di sản phẩm PCR khuếch đại gen (A) gen XRE (~ 246 bp) và (B) Cry2 (~ 700 bp)
Ghi chú: M: thang chuẩn marker 1 Kb; (-) Đối chứng trắng; 1: Bacillus subtilis (ATCC 79530); 2: Bacillus amyloliquefaciens (mẫu phân lập đã giải trình tự); 3: Staphylococcus aureus (ATCC 25923), 4: E. coli (ATCC 85922).
Thư mục tài liệu tham khảo
[1] Health Protection Agency (2004). Enumeration of Bacillus cereus and other Bacillus species. National standard Method F 15 Issuel.
[2] UK Standards for Microbiology Investigations (2018). Identification of Bacillus species. Issued by the Standards Unit, Microbiology Services, Public Health England. Bacteriology - Identification, ID 9, Issue no: 3.1, Issue date: 04.04.18, Page 1 -27.
[3] Sharif F:A. and Alaeddinoglu N.G. (1998) A rapid and simple method for staining of the crystal protein of Bacillus thuringiensis. Journal of Industrial Microbiology 3: 227-229.
[4] Travers R.S, Martin P.A, Reichelderfer C.F. (1987.) Selective Process for Efficient Isolation of Soil Bacillus spp. Applied and Environmental Microbiology 53: 1263-1266.
[5] Masoomi Aladizgeh, F., Jabbari, L, Khayam Nekouei, R., & Aalami, A. (2016). A simple and rapid system for ADN and RNA isolation from diverse plants using handmade kit. Protocol Exchange. https://doi.org/10.2f203/rs.2.1347/v2
[6] Chelliah R., Wei S., Park B.J., Rubab M., Banan-Mwine D.E., Barathikannan K. Jin Y.G and Oh D.H. (2019). Whole genome sequence of Bacillus thuringiensis ATCC 10792 and improved discrimination of Bacillus thuringiensis from Bacillus cereus group based on novel biomarkers. Microbial Pathogenesis 129: 284-297.
[7] TCVN 12105:2018. Phân bón vi sinh vật - Lấy mẫu.
Bạn chưa Đăng nhập thành viên.
Đây là tiện ích dành cho tài khoản thành viên. Vui lòng Đăng nhập để xem chi tiết. Nếu chưa có tài khoản, vui lòng Đăng ký tại đây!